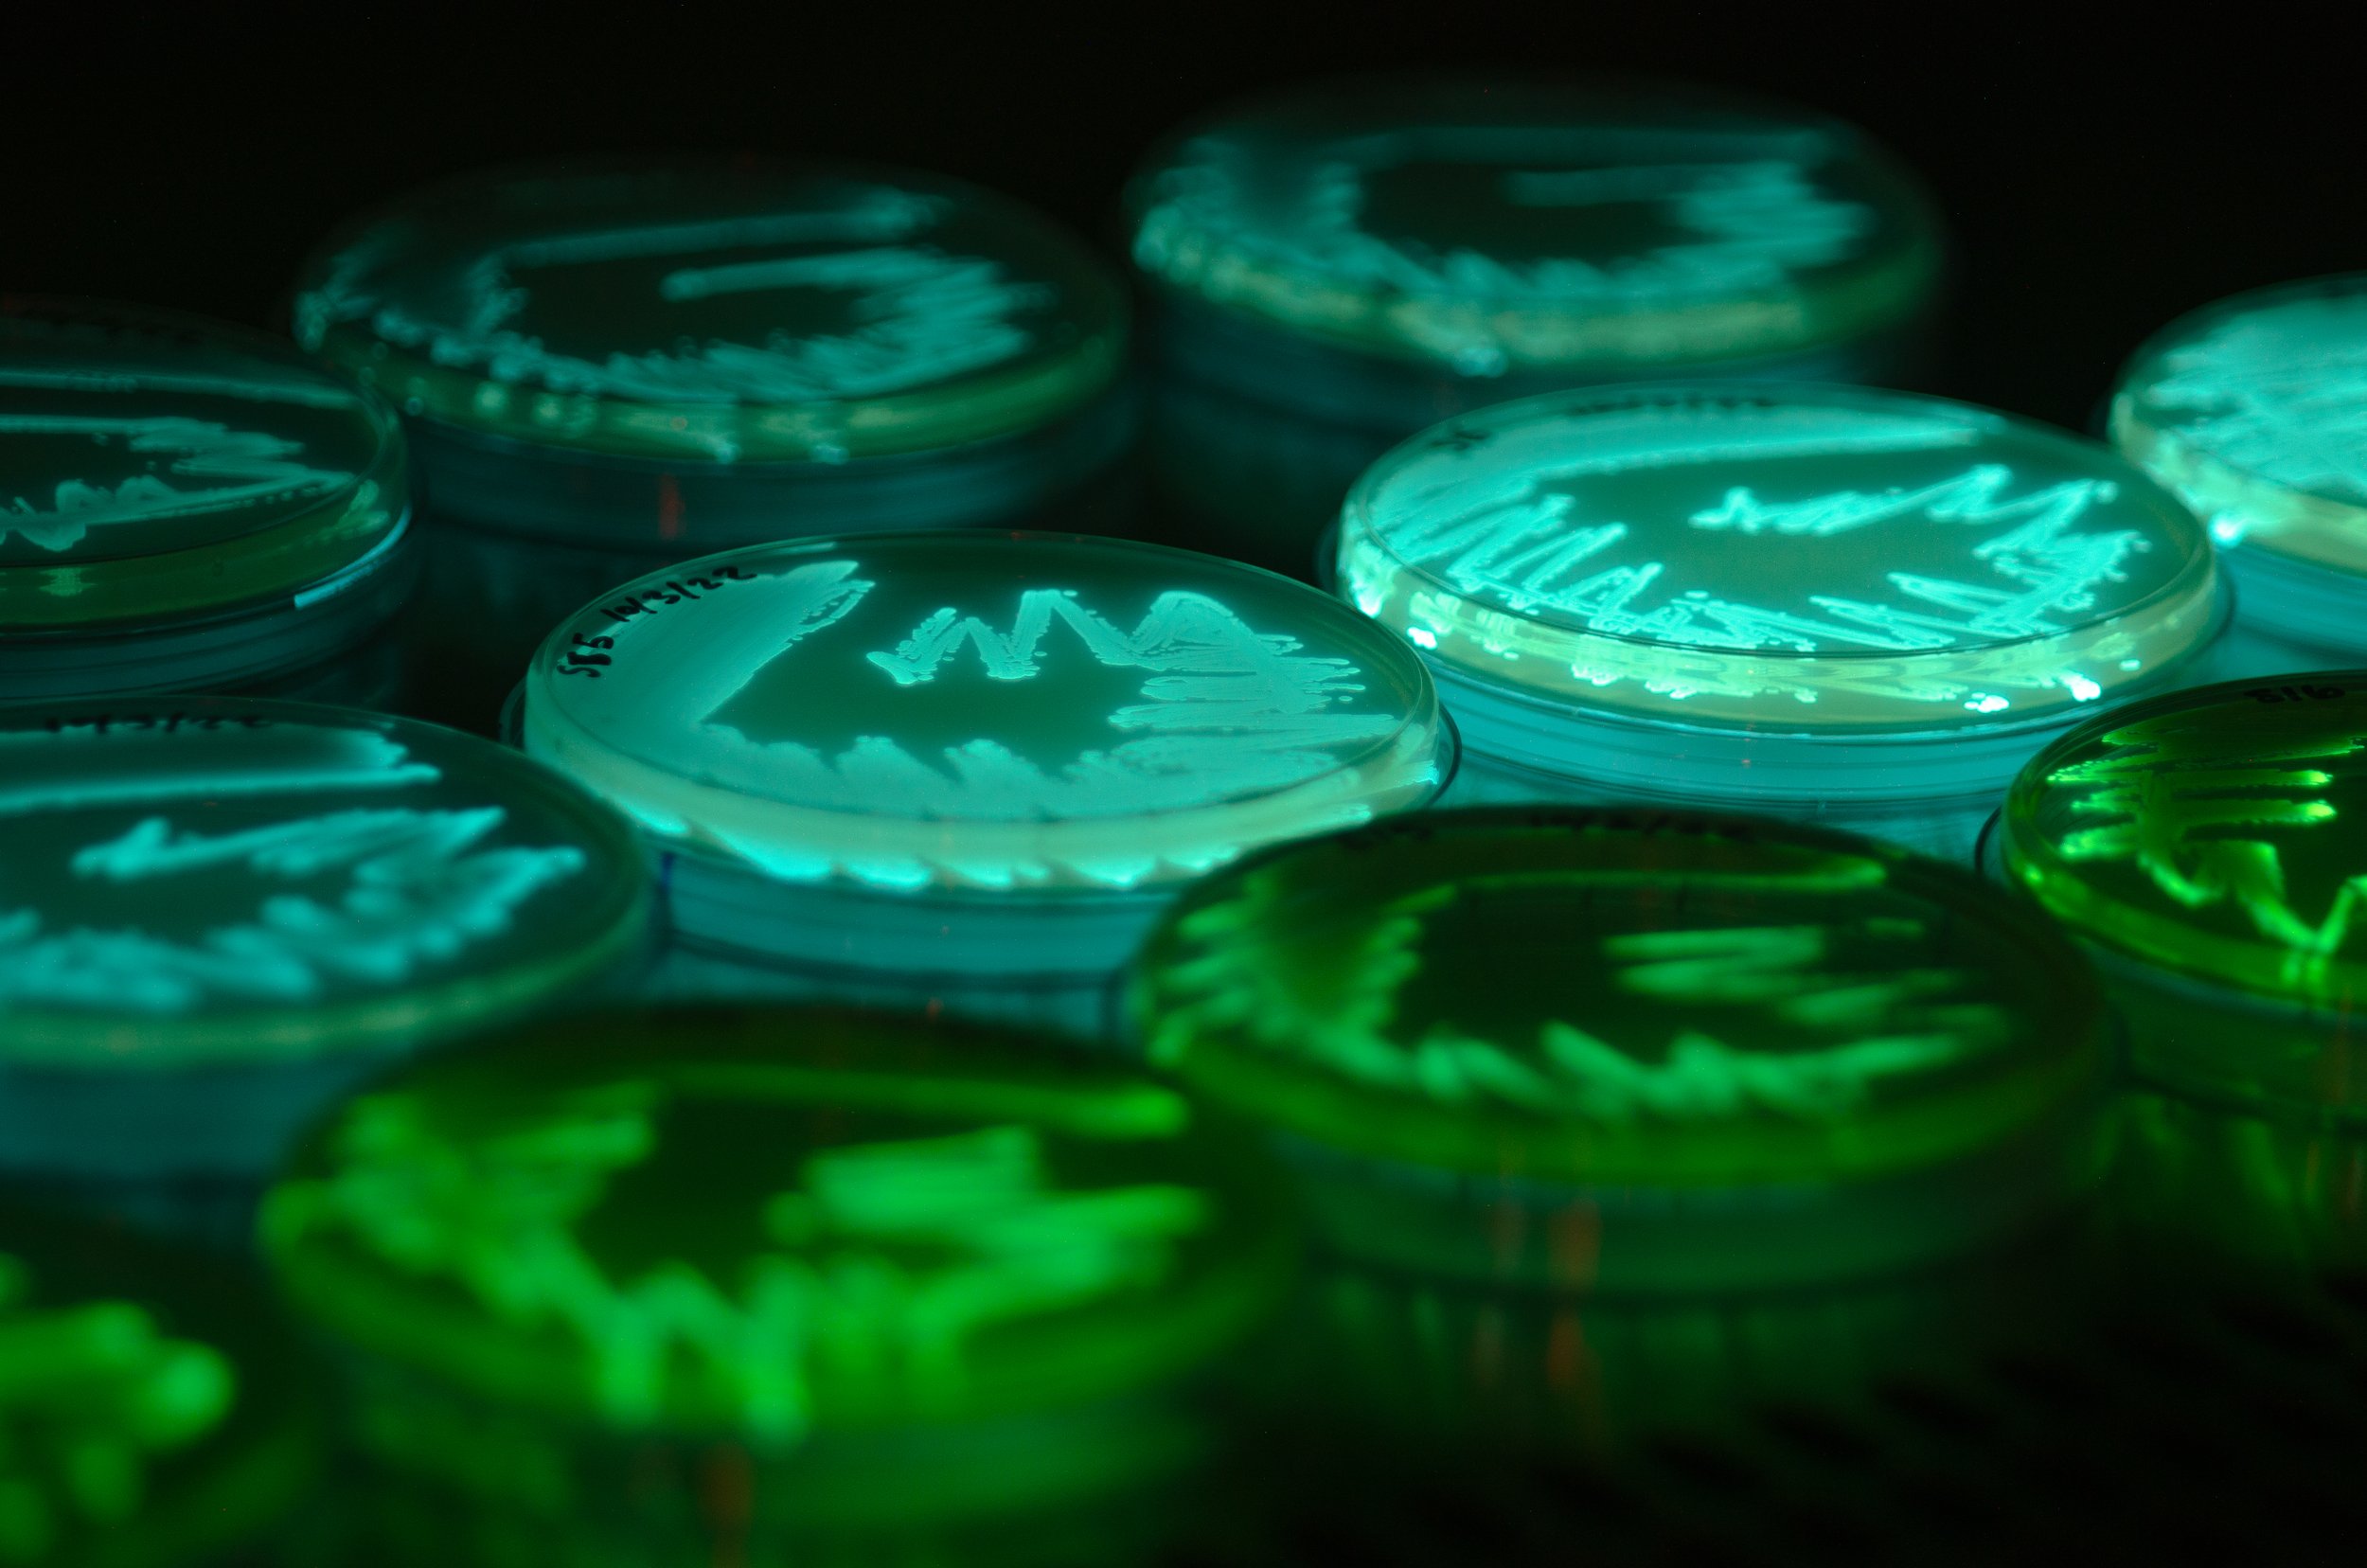

We are investigating the ecological processes involved in symbiont community assembly in the Siphamia-Photobacterium symbiosis. Despite a high level of symbiont specificity, we have observed significant strain-level symbiont variation within fish light organs. Using PCR fingerprinting and whole genome sequencing, we are examining these strain-level differences between individual hosts and populations of hosts throughout the Indo-Pacific.
Fluorescence and bioluminescence
We are using fluorescently-labeled strains to investigate ecological factors, such as priority effects and strain competition, that shape the symbiont community within a light organ. Photo: GFP-labelled strains next to their wild-type (photo credit: Callie Chappell).